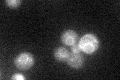
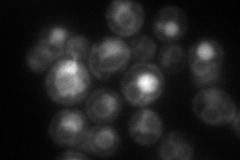
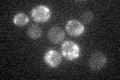

View description
Phospholipid methyltransferase (methylene-fatty-acyl-phospholipid synthase), catalyzes the last two steps in phosphatidylcholine biosynthesis
Localization:
Intensity:
Fold change:
Significance:
-
C’ GFP library in SD
ER29.3 -
N' NOP1pr-GFP in SD

ER,punctate74.5695 -
N' TEF2pr-mCherry in SD
ER,vacuole97.5676 -
N' NATIVEpr-GFP in SD

punctate,ER63.0103 -
N' TEF2pr-VC and Cyto-VN in SD

below threshold22.6913 -
C’ GFP library in SD+DTT

ER41.041.4Yes -
C’ GFP library in SD+H2O2

ER18.080.61Yes -
C’ GFP library in Starvation Media
ER200.68Yes -
C’ GFP library on the background of Pup2-DaMP

N/A -
C’ GFP library on the background of CCT mutant

N/A0N/AYes
